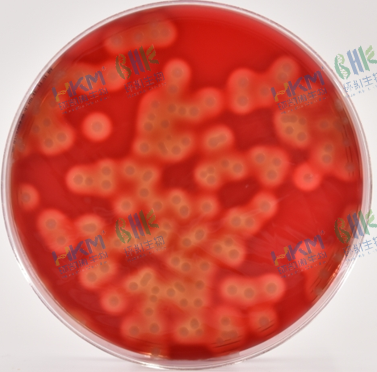

GB4789.11-2014 β型溶血性链球菌检验及其注意事项
发布时间:2024-06-12 浏览次数:3907 分享:
β型溶血性链球菌的生物学特性
β型溶血性链球菌:链球菌属中一类在血平板上能形成β型溶血圈的细菌,以酿脓(或A群)链球菌及无乳(或B群)链球菌为主。

生物学特性:革兰氏阳性菌,呈球形或椭圆形,呈链状排列,长短不一,从4-8个至20-30个菌细胞组成不等,链的长短与细菌的种类及生长环境有关。该菌不形成芽孢,无鞭毛,需氧或兼性厌氧菌,营养要求较高。
流行学特征:广泛分布于自然界、人及动物粪便和健康人的鼻咽部。可通过直接接触、空气飞沫传播或通过皮肤、粘膜伤口感染,被污染的食品如奶、肉、蛋及其制品也会对人类进行感染。上呼吸道感染患者、人畜化脓性感染部位β型常成为食品污染的污染源。

对人毒力较强,产生β型溶血的A群链球菌引起化脓性感染、中毒性疾病及超敏反应性疾病。产生β型溶血的B群链球菌能引起牛乳房炎,严重危害畜牧业,该菌也能感染人类,尤其是新生儿可引起败血症、脑膜炎、肺炎等,死亡率极高,并可产生神经系统后遗症。
β型溶血性链球菌的检验

操作注意事项
1:当对易产生较大颗粒的样品(如肉类)进行检测时,建议使用带 滤网均质袋,以方便均质后用吸管吸取匀液;
2:使用均质袋进行前增菌时,应使用带有底托的均质袋架子,防止培养过程中前增菌袋子歪倒泄漏污染培养箱;
3:在使用VITEK2 Compact全自动微生物分析系统进行鉴定时,应结合其他生物学特性综合评价后判断结果。如遇待测菌鉴定评分过低,多个生化反应结果不符货48h生化反应仍不明显的情况,应考虑链球菌乳化程度不够,呈颗粒状,不能形成均匀的菌悬液有关,此时应重复试验或改用其它方法鉴定;
4:培养箱中叠放培养皿时,为防止中间平皿过热,高度不得超过6个平板。
培养基原理解析
▶ 胰蛋白胨、植物蛋白胨提供氮源、维生素和生长因子;葡萄糖提供碳源;磷酸氢二钾为缓冲剂;氯化钠维持均衡的渗透压;多粘菌素及萘啶酮酸用于抑制非链球菌的生长。

2、哥伦比亚CNA血平板
▶ 酵胰酪蛋白胨、动物组织 蛋白消化液、酵母提取物、牛肉提取物、淀粉提供碳氮源、维生素和生长因子;羊血是细菌生长繁殖的良好营养物质。在45~50℃的基础培养基中加入血液可以保存血液中某些不耐热的生长因子,同时血球不被破坏。琼脂是凝固剂,多粘菌素B、萘啶酸能抑制杂菌生长。
灰白色、半透明、光滑、圆形边缘整齐菌落,具有无色透明的溶血环
生化鉴定原理解析
1、触媒试验
▶ 大多需氧和兼性厌氧菌均产生过氧化氢酶,但链球菌属阴性,故常用此试验来鉴定。
▶ 结果判读:立即产生气泡+,不产生气泡-。
▶ 不宜用血平板上生长的菌落,因红细胞含有过氧化氢酶,可致假阳性反应。

β型溶血性链球菌 触酶+
2、链激酶试验
▶ 健康人的血浆中含有一种酶原,称为胞浆原。胞浆原在正常状态下不活动,如被溶血性链球菌产生的激活酶作用后,胞浆原即变为活动性的胞浆素,能溶解纤维蛋白。
▶ 结果判读:血浆混合物凝固后36±1℃继续培养24小时,凝块重新溶解为阳性。
质量控制及疑难解析
质量控制
1、实验室过程中,每批预增菌液、选择性增菌液、分离平板等都要做空白对照。以掌握检验过程中是否存在来自检验环境的污染。
2、定期使用β型溶血性链球菌ATCC19615或相应定量活菌参考品,在P2实验室或阳性对照实验室内,用适当的食品样品进行阳性实验验证,污染剂量应控制在10-100CFU/25g,并进行记录,验证实验至少每2个月进行1次。
3、每2个月将所使用的培养基和生化试剂用的标准菌株或阴性菌株进行验证,并进行记录。
疑难解析
问:在前增菌或选择性增菌结束后,肉汤未见微生物生长,是否可以终止实验?
答:不可以,因为肉汤可见的细菌浓度为107CFU/ml,在此浓度一下,肉眼不能发现微生物生长,但实际溶液中有微生物生长。
问:β型溶血性链球菌和乙型溶血性链球菌是一种菌吗?
答:是的,同一种不同名称。
问:β型溶血性链球菌为什么要在厌氧条件下培养?
答:厌氧条件下哥伦比亚CAN选择性琼脂平板更适合溶血性链球菌的分离培养,主要表现为菌落形态典型、溶血现象更为明显,同时抑制了需氧菌及干扰菌的生长。
所需培养基试剂
用途 | 货号 | 名称 | 规格 |
增 菌 | 024051 | 胰蛋白胨大豆肉汤(TSB) | 250g/瓶 |
024051P1 | 胰蛋白胨大豆肉汤(TSB) | 250g/瓶 | |
SR0310 | 改良胰蛋白胨大豆肉汤培养基配套试剂 | 10支/盒 | |
平 板 分 离 | 024066 | 哥伦比亚琼脂培养基 | 250g/瓶 |
SR0420 | 哥伦比亚CNA血琼脂配套试剂 | 10支/盒 | |
CP0910 | 哥伦比亚CAN血平板 | 90mm×20个 | |
纯 培 养 | 024061 | 哥伦比亚琼脂培养基 | 250g/瓶 |
CP0160 | 哥伦比亚血平板 | 90mm×20个 | |
生化鉴定 | 029180 | 革兰氏染色液 | 10mL×4瓶 |
029270 | 冻干草酸钾兔血浆 | 10支/盒 | |
029280 | 0.25%氯化钙溶液 | 10支/盒 |






